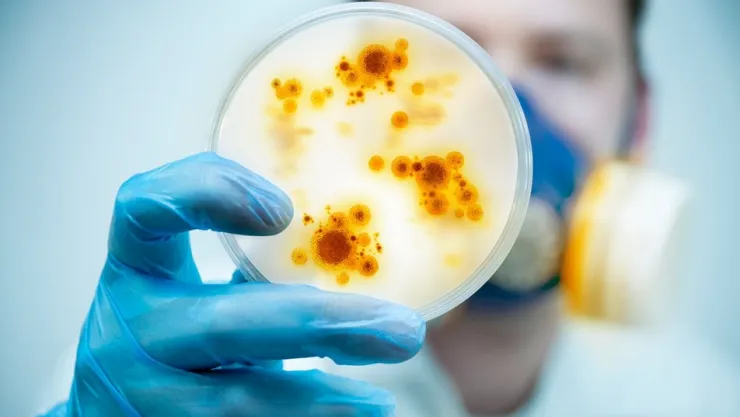
Farklı virüs endişesi!

İstanbul Medeniyet Üniversitesi (İMÜ) BİLTAM Laboratuvarı ve TÜBİTAK-MAM Gen Mühendisliği Enstitüsü’nden 7 bilim insanının yaklaşık 2 ay süren çalışması sonucu İstanbul’daki hastalardan alınan Kovid-19 virüsünün genetik haritası çıkarıldı. İMÜ Tıp Fakültesi Öğretim Üyesi ve Rektör Yardımcısı Prof. Dr. Sadrettin Pençe’nin yürüttüğü çalışma, virüsün genom mutasyonlarının izlenmesi, mutasyonlara karşı tanı testlerinin performansının revize edilmesi ve aşı ya da ilaç geliştirilmesi gibi konulara ışık tutacak. Çalışmanın ilk sonuçlarına göre İstanbul’daki hastalardan izole edilerek genetik haritası çıkarılan virüs, Avrupa kaynaklı. Prof. Dr. Pençe, “Çalışma Mart ayında başladı. Geçtiğimiz ay ilk aşamasını tamamladık. 4 hastadan aldığımız virüsün genetik dizilemesini yaparak National Center for Biotechnology Information (NCBI) gen bankasına yükledik. Salgın başladığından beri tüm dünyadan sonuçlar yükleniyor ve karşılıklı bilgi alışverişinde bulunuluyor. Ülkelerarası mutasyon farkı olup olmadığı tespit ediliyor. Şimdiye dek yüklenmiş tüm gen haritaları ile ülkemizdeki koronavirüsü karşılaştırdık ve virüslerin Avrupa kökenli olduğunu bulduk” dedi. “ÜRETİLECEK PCR TESTLRİ BUNA GÖRE REVİZE EDİLMELİ” Prof. Dr. Pençe, İstanbul’daki hastalardan elde edilen virüslerdeki mutasyonun, hastalık yapma şiddetine herhangi bir etkisinin olmadığını anlatarak “Bu fark şu açıdan önemli. Üretilecek yeni PCR testleri bu mutasyonlara göre revize edilmeli. Aksi taktirde yalancı negatif sonuçların önüne geçemeyiz ve bu da zincir şeklinde tedaviyi, hatta filyasyonu, dolayısıyla salgınla mücadeleyi olumsuz etkileyebilir. Ayrıca sadece ülke ya da bölgeler arası değil; şehirlerarası bile virüs farklılık gösterebiliyor. Örneğin İstanbul'daki virüs ile Kayseri'de de bir çalışma var; oradaki virüs aynı değil. Örneğin Van'da da muhtemelen farklı bir mutasyon dizisi olacaktır. Bizim bununla ilgili de bir proje çalışmamız var yine TÜBİTAK ile birlikte. Bütün Türkiye'yi kapsayan bir koronavirüs genom haritası çıkaracağız” diye konuştu. “MUTASYON 'N' GENİNDE.. BU GENİ KULLANAN TESTLER YANLIŞ SONUÇ VERİR” Prof. Dr. Pençe, “Zaten şu anda binlerce mutasyon var. Bunun fonksiyonel analizini yapmak gerekiyor. Bu da hastalığın şiddetinde herhangi bir değişikliğe neden olup olmadığını tespit etmek anlamına geliyor. Virüs genomundaki bu farklı dizilim hastalığın kliniğini etkilemese de bu dizilimi kullanan tanı kitlerinin sonuçlarını etkiler. Dolayısıyla değişik bölgelerdeki hastalardan alınan virüs düzenli aralıklarla taranmalı ve PCR testleri de belirlenen bu mutasyonlara göre yeniden düzenlenmeli. Kovid-19’da iki tanı aracı var. Biri antijen-antikor tanı kitleri, diğeri de genetik tabanlı tanı kitleri, yani PCR testleri. Bizim tespitlerimizde, N geninde mutasyon bulduk. Eğer tanı kiti bu, N geni üzerinden çalışıyorsa, Türkiye'de doğru sonuç alamazsınız demek olur” dedi. “YANLIŞ PCR SONUCU SALGINLA MÜCADELEYİ TOPTAN ETKİLEYEBİLİR” PCR testlerinin yanlış sonuç verebilmesinin, tüm dünyada tartışılan bir konu olduğuna değinen Prof. Dr. Pençe şunları vurguladı: “Bakıyorsunuz hasta ön tanı olarak Kovid pozitif, hastanede tedavi görüyor ancak PCR testi negatif çıkıyor. Çin, İngiltere, İtalya, Almanya, ABD, dünyanın her yerinden pekçok makale var bununla ilgili. Nedenleri hala tartışılıyor. Nedenler arasında dört etken konuşuluyor; uygun sürüntü alınmıyor, sürüntü uygun şekilde taşınmıyor, RNA izolasyonu uygun yapılmıyor veya bu testler emin ellerde çalışılmıyor. Biz bu çalışmamız ile bunlara beşincisini ekliyoruz ve diyoruz ki PCR tanı kitleri virüsteki bu mutasyonlara göre düzenli olarak revize edilmezse, pozitif bir hastanın sonucu negatif çıkabilir. Bunun için de birkaç ayda bir, düzenli bir şekilde virüsün genetik diziliminin yapılması lazım. Hatta ülkemizin çeşitli bölgelerinden, örneğin İstanbul'dan, Erzurum'dan, Gaziantep'ten, koronavirüs genleri dizilenip oradan çıkacak mutasyonlar dikkate alınarak PCR kitleri dizayn edilmeli.” “D614G MUTASYONU TÜRKİYE’DEKİ VİRÜSÜ DAHA ÖLÜMCÜL YAPMADI” Çalışmanın bir diğer aşamasının da hastalığın neden herkeste farklı etki gösterdiğinin tespit edilmesi olduğunun altını çizen Prof. Dr. Sadrettin Pençe, sözlerini şöyle tamamladı: “Koronavirüs niçin bir kısım insanda semptom oluşturuyor, bir kısım insanı entübe ettiriyor, bir kısım insanı yoğun bakımda yatırıyor, bir kısım insanda da hiç semptom oluşturmuyor? Bunun cevabını aramak istiyoruz. Yine bu günlerde dünya gündeminde de tartışılan konulardan biri de D614g mutasyonu. Amerika ve Avrupa’da bu mutasyonun görüldüğü ülkelerde hastalığın daha ölümcül seyrettiği yönünde tartışmalar var. Ancak bu da tam olarak doğruyu yansıtmıyor çünkü sayısal biyoloji kullanılarak yapılan bir modelleme çalışmasının sonucu bu. Bu genetik dizilim yeni ortaya çıkmış değil. İlk makale 26 Ocak'ta yayınlandı. Daha sonra da birçok çalışmada bu mutasyon görüldü. Ama bu son tartışmalar, yeni bir makalede bu mutasyonun, virüsün virulansında (hastalık şiddeti) artmaya neden olduğunu söylüyorlar. Oysa biz de aynı dizilimi tespit ettik. İzlediğimiz 4 hastanın virüsünde de bu mutasyonlar mevcuttu. Ama hastalık yapma şiddetinde herhangi bir değişiklik olmadığını gördük. Mutasyon tek başına bir şey ifade etmez, bir mutasyonun fonksiyonel analizi önemlidir. Bu da klinikteki sonuçlarını tespit etmek anlamına gelir. Biz önce fonksiyonel modelleme yapıyoruz daha sonra klinik sonuçlarıyla bunu karşılaştırıyoruz. Bizim karşılaştırmamızda böyle bir etki yok.”
WhatsApp İhbar Hattı
0538 483 25 53
ÇEKİN, GÖNDERİN, YAYINLAYALIM!